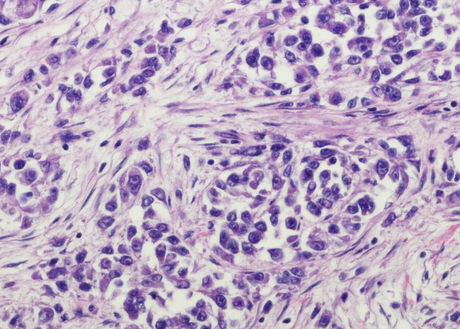

FDA approves first gene therapy to treat adults with metastatic synovial sarcoma
What is the potential role for afami-cel in the treatment of unresectable or metastatic synovial sarcoma?
- Afami-cel is the first FDA-approved T cell receptor (TCR) gene therapy approved for adults with unresectable or metastatic synovial sarcoma who have received prior chemotherapy, are positive for HLA antigen(s) A*02:01P, -A*02:02P, -A*02:03P or A*02:06P, and whose tumor expresses the MAGE-A4 antigen. Afami-cel was approved under the accelerated approval pathway.
- Synovial sarcoma is a rare mesenchymal malignancy, that tends to have poor outcomes once it metastasizes. Overall survival (OS) of this population remains relatively low (~15%).1 This rate becomes even lower in patients who receive second-line therapy.2
- Afami-cel is the first-in-class approval for T-cell receptor (TCR) therapy. Although TCR therapy shares some similarities with chimeric antigen receptor (CAR) T-cell therapy, it has a distinct mechanism of action. CAR T-cell therapies use a synthetic receptor introduced into immune effector cells to recognize abnormal tumor cell surface proteins, whereas TCR therapy uses a modified form of a naturally occurring receptor which allows it to bind to tumor-specific epitopes presented by major histocompatibility complex molecules on the surface of tumor cells. Therefore, TCR therapy opens the door to new intracellular targets found within malignant cells. 3
- Afami-cel is an autologous CD4+ and CD+ T-cell immunotherapy that is genetically modified to express an affinity-enhanced MAGE-A4-specific T-cell receptor. Melanoma-associated antigen A4 (MAGE-A4) is an intracellular cancer-testis antigen commonly expressed in solid tumors including synovial sarcoma. The antigen-specific activation of afami-cel results in T-cell proliferation, cytokine secretion and killing of MAGE-A4 expressing synovial sarcoma cells.4,5
- Afami-cel is the first gene-therapy approved for solid tumors in the US and is the first new therapy approved for synovial sarcoma in over a decade. The safety and efficacy of afami-cel was evaluated in the SPEARHEAD-1 multicenter, single-arm, non-randomized, open label phase 2 clinical trial. The SPEARHEAD-1 trail included 44 patients who received a single IV dose of afami-cel (dose range 1.0x109 - 10.0 x 109 T cells) after lymphodepletion with fludarabine and cyclophosphamide.6
- The primary endpoint of overall response (OR) was achieved in 43.2% of participants with synovial sarcoma. Only 4.5% of patients achieved a complete response (CR), however, the study population was heavily pre-treated (median of three previous lines of systemic therapy). The median duration of response was 6 months.6
- Currently, afami-cel’s place in therapy has not been incorporated into NCCN guidelines for treatment of synovial sarcoma.7 First-line therapy for advanced or metastatic disease consists of anthracycline-based regimens or alternatives such as gemcitabine or pazopanib for those unable to tolerate anthracyclines. Subsequent lines of therapy may include pazopanib, eribulin, trabectedin or gemcitabine and docetaxel.7,8
- Acknowledging the limitations of cross-trial comparisons, the OR in SPEARHEAD-1 was favorable compared to other studies evaluating treatment for refractory synovial sarcoma.9,10 Continued FDA approval may be contingent on additional data confirming clinical benefit.
- Costs and availability of afami-cel may limit use.
- Afami-cel should only be considered as a treatment option for patients who have unresectable or metastatic disease and who have failed systemic chemotherapy.
What role can the pharmacist play in the management of patients on afami-cel?
- Pharmacists can play a crucial role in caring for patients on afami-cel through the management of toxicities. Pharmacists monitor patients for potential side effects and track laboratory values. Additionally, they coordinate the delivery and proper storage of the medication to ensure it is handled appropriately.
- Prior to afami-cel infusion, a lymphodepleting regimen should be started on Day -7 consisting of fludarabine 30 mg/m2/day IV for 4 days and cyclophosphamide 600 mg/m2/day IV for 3 days.5
- Premedicate before afami-cel infusion with H1 antihistamine and acetaminophen. Avoid prophylactic systemic corticosteroids.5
- The recommended dose is between 2.68 x 109 - 10 x109 MAGE-A4 T cell receptor positive T cells as a single dose.5
- There are no known drug interactions.5
- Cytokine release syndrome (CRS) occurred in 75% of the 44 patients with 1 patient experiencing grade 3 CRS.5,6
- Monitor patients for at least 7 days in a healthcare facility after infusion.
- Manage with supportive care, tocilizumab, and/or corticosteroids as indicated by current practice guidelines.11
- Immune effector cell-associated neurotoxicity syndrome (ICANS) occurred in 2% of the 44 patients (grade 1).5,6
- Monitor for at least 4 weeks after treatment.
- Advise patients to refrain from driving and engaging in hazardous occupations or activities, such as operating heavy or potentially dangerous machinery, for at least 4 weeks after treatment.
- Manage based on toxicity grade per current practice guidelines.
- Cytopenias were the most common adverse events: lymphopenia occurred in 98% of patients, neutropenia in 96%, and leukopenia in 96%.5,6
- Patients with grade 3 or greater cytopenias not resolved by week 4 included thrombocytopenia (5%), anemia (9%), and neutropenia (11%).
- Monitor blood counts after afami-cel infusion. Administer granulocyte-colony stimulating factor and blood product infusions as indicated by current practice guidelines.
- Infections of any grade occurred in 32% of the 44 patients. Grade 3 or higher infections occurred in 14% of patients.5,6
- Monitor for signs and symptoms of infections before and after afami-cel infusion and treat appropriately.
- Consider antibacterial, antifungal, and antiviral prophylaxis per current practice guidelines
- Contact AdaptimmuneAssist by calling 1-855-24MYADAP or emailing adaptimmuneassist@adaptimmune.com to connect with a treatment navigator and for patient copay assistance.13
Clinical Pearls
- Afami-cel is supplied in one or more infusion bag(s). Afami-cel is shipped in a liquid nitrogen dry vapor shipper at less than or equal to -130°C and should be stored in the original packaging in the vapor phase of liquid nitrogen at less than or equal to -130°C. Administer each infusion bag within one hour of thawing.5
- Afami-cel is contraindicated in patients who are heterozygous or homozygous for HLA-A*02:05P. Afami-cel should only be used in patients positive for HLA-A*02:01P, HLA-A*02:02P, HLA-A*02:03P, and 383 HLA-A*02:06P alleles whose tumor expresses the MAGE-A4 tumor antigen.5,6
- Previous recipients of allogenic hematopoietic stem cell transplants were excluded from the SPEARHEAD-1 trail and should not be considered for treatment with afami-cel.6
- Due to the relatively long production time of afami-cel (at least 6 weeks), bridging therapy may be needed between leukapheresis and lymphodepletion therapy. However, they may require washout periods (4 weeks for immunotherapy or investigation drugs, 3 weeks for cytotoxic chemotherapy, 2 weeks for corticosteroids or other immunosuppressive drugs and 1 week for tyrosine kinase inhibitors). Thirty-six percent of patients in the SPEARHEAD-1 trial received bridging therapy, with pazopanib being the most common agent used. However, absence of bridging therapy was associated with higher response rates.6
- SeCore CDx HLA Sequencing System is FDA approved for HLA testing. MAGE-A4 IHC 1F9 pharmDx is FDA approved for the detection of MAGE‑A4.12
References
1.Vlenterie M, Litière S, Rizzo E, et al. Outcome of chemotherapy in advanced synovial sarcoma patients: Review of 15 clinical trials from the European Organisation for Research and Treatment of Cancer Soft Tissue and Bone Sarcoma Group; setting a new landmark for studies in this entity. Eur J Cancer. 2016;58:62-72. doi:10.1016/j.ejca.2016.02.002
2.Kojima Y, Shimoi T, Seo T, et al. Poor Treatment Outcomes with Second-Line Chemotherapy in Advanced Synovial Sarcoma. Oncology. 2022;100(7):370-375. doi:10.1159/000524500
3.Tsimberidou A-M, Van Morris K, Vo HH, et al. T-cell receptor-based therapy: an innovative therapeutic approach for solid tumors. J Hematol Oncol. 2021;14(1):102. doi:10.1186/s13045-021-01115-0
4.Hong DS, Van Tine BA, Biswas S, et al. Autologous T cell therapy for MAGE-A4+ solid cancers in HLA-A*02+ patients: a phase 1 trial. Nat Med. 2023;29(1):104-114. doi:10.1038/s41591-022-02128-z
5.Tecelra (afamitresgene autoleucel) [Package Insert]. Philadelphia, PA: Adaptimmune LLC; 2024.
6.D'Angelo SP, Araujo DM, Abdul Razak AR, et al. Afamitresgene autoleucel for advanced synovial sarcoma and myxoid round cell liposarcoma (SPEARHEAD-1): an international, open-label, phase 2 trial. Lancet. 2024;403(10435):1460-1471. doi:10.1016/S0140-6736(24)00319-2
7.National Comprehensive Cancer Network. Soft Tissue Sarcoma (Version 2.2024). https://www.nccn.org/professionals/physician_gls/pdf/sarcoma.pdf. Accessed September 23, 2024
8.Stacchiotti S, Van Tine BA. Synovial Sarcoma: Current Concepts and Future Perspectives. J Clin Oncol. 2018;36(2):180-187. doi:10.1200/JCO.2017.75.1941
9.Savina M, Le Cesne A, Blay JY, et al. Patterns of care and outcomes of patients with METAstatic soft tissue SARComa in a real-life setting: the METASARC observational study. BMC Med. 2017;15(1):78. Published 2017 Apr 10. doi:10.1186/s12916-017-0831-7
10.Sleijfer S, Ray-Coquard I, Papai Z, et al. Pazopanib, a multikinase angiogenesis inhibitor, in patients with relapsed or refractory advanced soft tissue sarcoma: a phase II study from the European organisation for research and treatment of cancer-soft tissue and bone sarcoma group (EORTC study 62043). J Clin Oncol. 2009;27(19):3126-3132. doi:10.1200/JCO.2008.21.3223
11.Lee DW, Gardner R, Porter DL, et al. Current concepts in the diagnosis and management of cytokine release syndrome. Blood. 2014;124(2):188-195. doi:10.1182/blood-2014-05-552729
12.FDA. List of Cleared or Approved Companion Diagnostic Devices (In Vitro and Imaging Tools). https://www.fda.gov/medical-devices/in-vitro-diagnostics/list-cleared-or-approved-companion-diagnostic-devices-in-vitro-and-imaging-tools. Accessed September 23, 2024
13.Adaptimmune Assist. https://www.adaptimmuneassist.com/healthcare-providers. Accessed September 23, 2024.